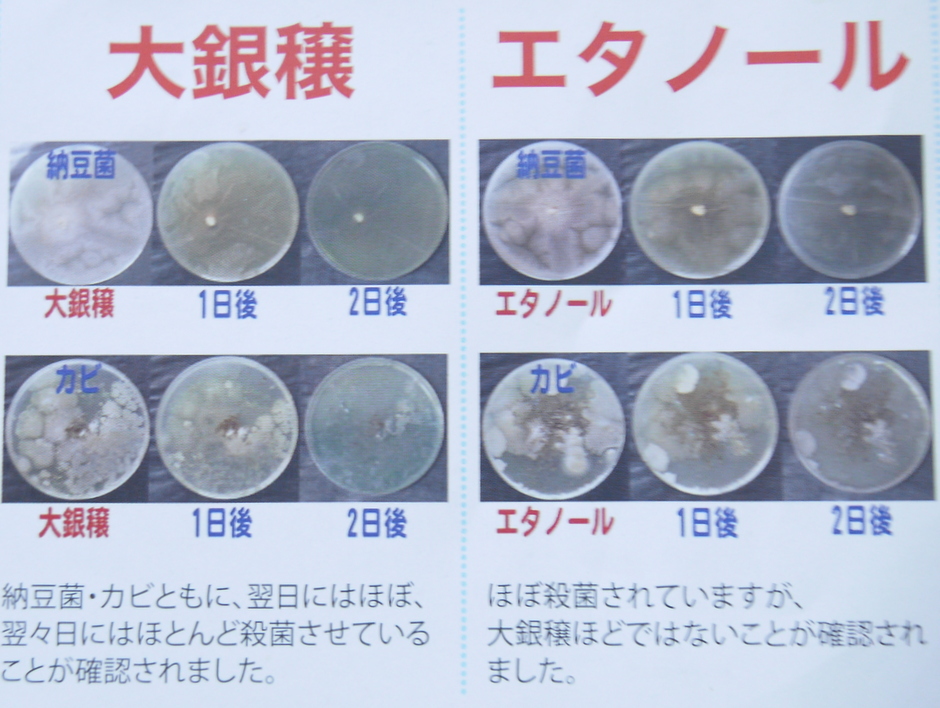

|
・。:゚*゚・。+スッキリ爽快!・+。:゚*・。・ おそうじレビューをつづっています |
 |
| *・゜*:.。..:* 絶賛リピート中 *:..。.:*゜・* | ||||||||
おそうじしながら地球も洗おう!ファンサイト参加中

地球洗い隊さまから、大銀穣を送っていただき、モニターに参加しています。
→ みんなのレビューで「大銀醸」の口コミをみる

地球洗い隊スタッフ川村さまからあたたかいメッセージを
いただきました。とてもうれしかったです


魔法のような除菌・消臭スプレー・大銀穣をご紹介します。

 使い方
使い方

水道水を入れるだけで銀イオン水が作れます。
100回以上、使い続けられ経済的です。
(チップは3年ほどでの交換がおすすめ。)
 パンフレットにかいてあった100回以上が気になったのでお問い合わせしてみました。
パンフレットにかいてあった100回以上が気になったのでお問い合わせしてみました。
Q.銀イオンは水を入れて100回以上使えるとかいてあったのですが、
うがいで毎日使っていたら100回は半年くらいで達成してしまいます。
100回過ぎると3年経っていなくても銀イオンの交換を行ったほうがいいのでしょうか?
Aコチラ↓のページにありますように
http://toreru.com/fs/araitai/c/gin_voice_faq#q_01
100回使ったら終わり、ということではありません。
なぜ「100」という数字が使われているのか、私も正直わかりません。
「100本分も使えるの!?」と驚いてもらうため・・・かな?
ただご案内したページでは、銀チップが崩れるまで「半永久的」な
印象がありますがチップにはフィルターのように小さな穴が空いているため
使い続けているうちに目詰まりしていきます。
そうすると効果が薄れていくので3年を目途に交換をオススメしています。
何度も使えるからケチケチしないで思いっきり使えるのがうれしい!!



 エタノールと大銀穣の比較実験です
エタノールと大銀穣の比較実験です
こんな方におすすめ
こんな方におすすめ

大銀穣は除菌・消臭が1本でできる銀イオン水♪

容器の中にチップが入っている状態でしたら、常に容器の中の水は
銀イオン水です。
また雑菌なども発生しませんので、腐らずそのままお使いいただけます。

スプレーノイズ自体は消耗品ですので定期的に交換してください。

 不思議な大銀穣の正体はこちら
不思議な大銀穣の正体はこちら
http://toreru.com/fs/araitai/c/removal_deo
 いろいろな場面で使用してみました。~♪ *^^* ♪
いろいろな場面で使用してみました。~♪ *^^* ♪

生活する上で困るのは、臭い!
地球洗い隊さまからメッセージをいただいたので、追加します。
「コップなどにお酢を少し入れた後、大銀穣をかけてみてください。
ニオイがなくなれば消臭効果あり!ですね。
ときどきこの実験をして、効果が持続しているか確認するといいかもしれません。
好奇心から実験してみました
酢を入れて、大銀穣をかけて
におってみるとほんとうに匂いが
きえていて感動しました。



 なかなか洗えないぬいぐるみの消臭に・・・
なかなか洗えないぬいぐるみの消臭に・・・

 毎日はく靴の消臭や・・・
毎日はく靴の消臭や・・・
地球洗い隊さまからメッセージをいただいたので、追加します。
靴も、革製のものはサッと一吹きくらいがいいかもしれません。


服の消臭にも・・・



ひざかけの消臭や・・・

 なかなか洗えない毎日使う枕のカバーや布団の除菌・消臭にも・・・
なかなか洗えない毎日使う枕のカバーや布団の除菌・消臭にも・・・
雨ばかりの梅雨時期は洗濯が乾かず、
カビも大量発生してとくに困る時期!
大銀穣が1本あれば、ココロ強いです!

 毎日ゴロゴロしているチェアや・・・
毎日ゴロゴロしているチェアや・・・

 ニオイのついているカーテンに・・・
ニオイのついているカーテンに・・・

 トイレの便器よりも多いと言われているパソコンマウスやキーボードの雑菌に・・・
トイレの便器よりも多いと言われているパソコンマウスやキーボードの雑菌に・・・
地球洗い隊さまからメッセージをいただいたので、追加します。
電化製品など水がNGな場所には気をつけたほうがいいようです。
パソコンには水気は厳禁です。
パソコンのキーボードに直接スプレーするとの原因になるかもしれません。
私自身、ハーブティ&紅茶を飲みながら、PCするのですが、
おもえば2014年の12月31日の大晦日、
しょうが湯をばっしゃんとかけてしまって故障させてしまったのでした。oh no!
予想外の出費でした。 → http://u111u.info/jpXS
キッチンペーパーやふきんに大銀穣を
ふきつけてお掃除するといいようです。
キーボードがよく汚れ困っていたので活用させていただきます。

父が若いころ弾いていて今は私がもらったギターにも・・・
地球洗い隊さまからメッセージをいただいたので、追加します。
ギターのような木材(?)にもご注意を。
楽器はデリケートなので、避けていただいたほうが無難だと思います。

 趣味でひいているエレクトーンに吹きかけて鍵盤を除菌
趣味でひいているエレクトーンに吹きかけて鍵盤を除菌
父の妹が音楽で身をたてているので、実家にいろいろな楽譜があり、
小さいころから音楽にふれる機会は多かったです。
エレクトーンも父の妹が置いていったものをわたしが使ってます。
地球洗い隊さまからメッセージをいただいたので、追加します。
エレクトーンに直接スプレーすると故障の原因になるかもしれません。
避けていただいたほうが無難だと思います。

 みえない雑菌がたくさん潜んでいるトイレの除菌や消臭に・・・
みえない雑菌がたくさん潜んでいるトイレの除菌や消臭に・・・
親戚が妊娠初期でいろいろなにおいを受けつけず、つわりに苦しんでいます。
香りがついている消臭剤が駄目なようで大の悪臭に困っていた彼女にも
大銀穣を教えてあげました。
においに敏感な妊婦さんにもココロ強い味方だと思います。
地球洗い隊さまからメッセージをいただいたので、追加します。
除菌の効果は目に見えませんが消臭については、確認することができます。
気になるニオイにかけてニオイが消えれば、それでOKです。
大銀穣は、ニオイでごまかすものではないので
人工的なニオイが苦手な方には、特に喜ばれると思います。

 カビのよくはえるお風呂のタイルのカビ予防にも・・・
カビのよくはえるお風呂のタイルのカビ予防にも・・・
お風呂のカビとりレビュー → http://urx3.nu/jiK6

 足の臭いが触れるマットレスの消臭・除菌に・・・
足の臭いが触れるマットレスの消臭・除菌に・・・
 気になるペットに匂い、体臭にシュッとするものいいですね♪
気になるペットに匂い、体臭にシュッとするものいいですね♪

歯ブラシにシュッとするのもいいですね♪
(ハミガキ粉の役目ではなく、除菌のため)

 毎日の日課、観葉植物の水やりや・・・
毎日の日課、観葉植物の水やりや・・・

 インフルエンザ対策の手洗いにも
インフルエンザ対策の手洗いにも
風邪をよくこじらすので習慣にし、風邪予防したいとおもいます。
お水も飲めるそうなので、ちょっとおそるおそる飲んでみました。
意外と甘くて美味しかったです
うがいをするのもいいそうですよ。
試しにうがいをしてみたら、口の中がさっぱりしました


 ふきんの除菌に・・・みえない菌がたくさんひそんでいます。
ふきんの除菌に・・・みえない菌がたくさんひそんでいます。
O-157やノロウィルス対策に台所の除菌はしっかりと行おうとおもいます。
キッチンの水まわりがよく汚れます。 → http://urx3.nu/jmOH
 汚れには、とれるNO.1を使っているのですが気になっていることがありました。
汚れには、とれるNO.1を使っているのですが気になっていることがありました。
QとれるNO.1と同時に使用した場合はどうなりますか?
A.とれるNO.1と同時にお使いいただくと、とれるNO,1の有益微生物の活動が
阻害されてしまいます。
同時のご使用はオススメできません。
とれるNO,1でお掃除したあとに、除菌・消臭のために大銀穣をスプレーして
いただくという使い方でしたら問題ないそうです。

スプレーに入れ替えて持ち歩くのもおすすめ♪
※容器の中に銀チップがない状態だと
2~3日で効果がなくなります。
その都度、移し替えれば問題ありません。
→ 詳しくはコチラ

大銀穣が1つあるだけでいろいろな用途に使えて困った悩みを改善してくれる!!
とても頼りになる存在!
 レポート提出後、地球洗い隊さまからメッセージをいただきました。
レポート提出後、地球洗い隊さまからメッセージをいただきました。
こんにちは! 地球洗い隊 本多桃です。
大銀穣の感想をありがとうございます。
とれるに続き、大銀穣も気に入っていただけたようでよかったです。
さっそくいろんなところにお使いくださっていますね~。
ただ、電化製品など
水がNGな場所にはお気を付けくださいね。
エレクトーンやパソコンのキーボードに直接スプレーすると
故障の原因になるかもしれません。
ギターのような木材(?)にもご注意を。
楽器はデリケートなので、避けていただいたほうが無難だと思います。
靴も、革製のものはサッと一吹きくらいがいいかもしれません。
スニーカー類は大丈夫だと思いますが。
私もテニスシューズには、けっこうかけています。
布製品や植物、お水を使う場所やカラダには
どうぞガンガンお使いくださいませ~。
うがいにもチャレンジされたんですねっ。
帰宅後のガラガラうがいはもちろんですが
寝る前や朝起きたときなどのぶくぶくうがいもオススメです。
口の中に向けてスプレーするだけでもいいですよ。
今回は加齢臭がテーマでしたが
体臭や寝具周りなどの消臭効果はいかがだったでしょうか。
機会がありましたら、教えていただけると嬉しいです。
※カビ取りのお掃除をされたんですね。
キレイになって、ホント、ピッカピカだぁ。
この後はぜひ、とれるでお掃除なさってくださいね。
手書きメッセージについても温かいお言葉をいただけて
発送担当の川村も喜びます~。
今後も、とれると大銀穣を日々の生活にお役立てくださいませ。
 レポートを丁寧によんでくださり、ありがとうございました。
レポートを丁寧によんでくださり、ありがとうございました。
 返信
返信
電化製品など水がNGな場所には
気を付けたほうがいいのですね。
今後、注意します。
口臭のレポートは健康の悩みを改善するコンセプトの別blogに飛びます。
→ http://urx3.nu/jmzP

自分で作れる消臭・除菌・抗菌スプレー【大銀醸】
http://toreru.com/fs/araitai/c/removal_deo
初期費用は高く感じるかもしれませんが
何度もつかえて経済的なところ
除菌・消臭効果があるのが
すごくいい!!




地球洗い隊さまから、大銀穣を送っていただき、モニターに参加しています。
→ みんなのレビューで「大銀醸」の口コミをみる
地球洗い隊スタッフ川村さまからあたたかいメッセージを
いただきました。とてもうれしかったです
魔法のような除菌・消臭スプレー・大銀穣をご紹介します。
水道水を入れるだけで銀イオン水が作れます。
100回以上、使い続けられ経済的です。
(チップは3年ほどでの交換がおすすめ。)
Q.銀イオンは水を入れて100回以上使えるとかいてあったのですが、
うがいで毎日使っていたら100回は半年くらいで達成してしまいます。
100回過ぎると3年経っていなくても銀イオンの交換を行ったほうがいいのでしょうか?
Aコチラ↓のページにありますように
http://toreru.com/fs/araitai/c/gin_voice_faq#q_01
100回使ったら終わり、ということではありません。
なぜ「100」という数字が使われているのか、私も正直わかりません。
「100本分も使えるの!?」と驚いてもらうため・・・かな?
ただご案内したページでは、銀チップが崩れるまで「半永久的」な
印象がありますがチップにはフィルターのように小さな穴が空いているため
使い続けているうちに目詰まりしていきます。
そうすると効果が薄れていくので3年を目途に交換をオススメしています。
何度も使えるからケチケチしないで思いっきり使えるのがうれしい!!
大銀穣は除菌・消臭が1本でできる銀イオン水♪
容器の中にチップが入っている状態でしたら、常に容器の中の水は
銀イオン水です。
また雑菌なども発生しませんので、腐らずそのままお使いいただけます。
スプレーノイズ自体は消耗品ですので定期的に交換してください。
http://toreru.com/fs/araitai/c/removal_deo
生活する上で困るのは、臭い!
地球洗い隊さまからメッセージをいただいたので、追加します。
「コップなどにお酢を少し入れた後、大銀穣をかけてみてください。
ニオイがなくなれば消臭効果あり!ですね。
ときどきこの実験をして、効果が持続しているか確認するといいかもしれません。
好奇心から実験してみました
酢を入れて、大銀穣をかけて
におってみるとほんとうに匂いが
きえていて感動しました。
地球洗い隊さまからメッセージをいただいたので、追加します。
靴も、革製のものはサッと一吹きくらいがいいかもしれません。

服の消臭にも・・・

ひざかけの消臭や・・・
雨ばかりの梅雨時期は洗濯が乾かず、
カビも大量発生してとくに困る時期!
大銀穣が1本あれば、ココロ強いです!
地球洗い隊さまからメッセージをいただいたので、追加します。
電化製品など水がNGな場所には気をつけたほうがいいようです。
パソコンには水気は厳禁です。
パソコンのキーボードに直接スプレーするとの原因になるかもしれません。
私自身、ハーブティ&紅茶を飲みながら、PCするのですが、
おもえば2014年の12月31日の大晦日、
しょうが湯をばっしゃんとかけてしまって故障させてしまったのでした。oh no!
予想外の出費でした。 → http://u111u.info/jpXS
キッチンペーパーやふきんに大銀穣を
ふきつけてお掃除するといいようです。
キーボードがよく汚れ困っていたので活用させていただきます。
父が若いころ弾いていて今は私がもらったギターにも・・・
地球洗い隊さまからメッセージをいただいたので、追加します。
ギターのような木材(?)にもご注意を。
楽器はデリケートなので、避けていただいたほうが無難だと思います。
父の妹が音楽で身をたてているので、実家にいろいろな楽譜があり、
小さいころから音楽にふれる機会は多かったです。
エレクトーンも父の妹が置いていったものをわたしが使ってます。
地球洗い隊さまからメッセージをいただいたので、追加します。
エレクトーンに直接スプレーすると故障の原因になるかもしれません。
避けていただいたほうが無難だと思います。
親戚が妊娠初期でいろいろなにおいを受けつけず、つわりに苦しんでいます。
香りがついている消臭剤が駄目なようで大の悪臭に困っていた彼女にも
大銀穣を教えてあげました。
においに敏感な妊婦さんにもココロ強い味方だと思います。
地球洗い隊さまからメッセージをいただいたので、追加します。
除菌の効果は目に見えませんが消臭については、確認することができます。
気になるニオイにかけてニオイが消えれば、それでOKです。
大銀穣は、ニオイでごまかすものではないので
人工的なニオイが苦手な方には、特に喜ばれると思います。
お風呂のカビとりレビュー → http://urx3.nu/jiK6
歯ブラシにシュッとするのもいいですね♪
(ハミガキ粉の役目ではなく、除菌のため)
風邪をよくこじらすので習慣にし、風邪予防したいとおもいます。
お水も飲めるそうなので、ちょっとおそるおそる飲んでみました。
意外と甘くて美味しかったです
うがいをするのもいいそうですよ。
試しにうがいをしてみたら、口の中がさっぱりしました
O-157やノロウィルス対策に台所の除菌はしっかりと行おうとおもいます。
キッチンの水まわりがよく汚れます。 → http://urx3.nu/jmOH
QとれるNO.1と同時に使用した場合はどうなりますか?
A.とれるNO.1と同時にお使いいただくと、とれるNO,1の有益微生物の活動が
阻害されてしまいます。
同時のご使用はオススメできません。
とれるNO,1でお掃除したあとに、除菌・消臭のために大銀穣をスプレーして
いただくという使い方でしたら問題ないそうです。
スプレーに入れ替えて持ち歩くのもおすすめ♪
※容器の中に銀チップがない状態だと
2~3日で効果がなくなります。
その都度、移し替えれば問題ありません。
→ 詳しくはコチラ
大銀穣が1つあるだけでいろいろな用途に使えて困った悩みを改善してくれる!!
とても頼りになる存在!
こんにちは! 地球洗い隊 本多桃です。
大銀穣の感想をありがとうございます。
とれるに続き、大銀穣も気に入っていただけたようでよかったです。
さっそくいろんなところにお使いくださっていますね~。
ただ、電化製品など
水がNGな場所にはお気を付けくださいね。
エレクトーンやパソコンのキーボードに直接スプレーすると
故障の原因になるかもしれません。
ギターのような木材(?)にもご注意を。
楽器はデリケートなので、避けていただいたほうが無難だと思います。
靴も、革製のものはサッと一吹きくらいがいいかもしれません。
スニーカー類は大丈夫だと思いますが。
私もテニスシューズには、けっこうかけています。
布製品や植物、お水を使う場所やカラダには
どうぞガンガンお使いくださいませ~。
うがいにもチャレンジされたんですねっ。
帰宅後のガラガラうがいはもちろんですが
寝る前や朝起きたときなどのぶくぶくうがいもオススメです。
口の中に向けてスプレーするだけでもいいですよ。
今回は加齢臭がテーマでしたが
体臭や寝具周りなどの消臭効果はいかがだったでしょうか。
機会がありましたら、教えていただけると嬉しいです。
※カビ取りのお掃除をされたんですね。
キレイになって、ホント、ピッカピカだぁ。
この後はぜひ、とれるでお掃除なさってくださいね。
手書きメッセージについても温かいお言葉をいただけて
発送担当の川村も喜びます~。
今後も、とれると大銀穣を日々の生活にお役立てくださいませ。
電化製品など水がNGな場所には
気を付けたほうがいいのですね。
今後、注意します。
口臭のレポートは健康の悩みを改善するコンセプトの別blogに飛びます。
→ http://urx3.nu/jmzP
自分で作れる消臭・除菌・抗菌スプレー【大銀醸】
http://toreru.com/fs/araitai/c/removal_deo
初期費用は高く感じるかもしれませんが
何度もつかえて経済的なところ
除菌・消臭効果があるのが
すごくいい!!
 |
。:゚*゚・。+SNSへはこちら・+。:゚*・。・
・。:゚*゚・。+Thank you very much・+。:゚*・。・
*pickup*
PR
*search*




